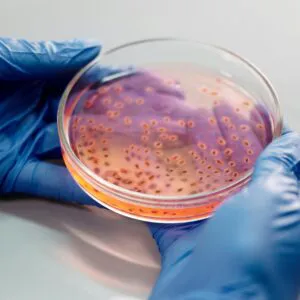
Bacteria

CRO Infectious Disease
KCI Biotech offers state-of-the-art CRO solutions for infectious diseases from our AAALAC-accredited facilities. Our extensive supply chain, efficient manufacturing processes, and robust laboratory platforms ensure comprehensive support for your preclinical research needs.
Get a Quote
Our Advantages
Expertise in Infectious Diseases
Our specialized team has extensive knowledge in infectious disease research, offering a depth of expertise that ensures high-quality outcomes and innovative solutions tailored to your specific project requirements.
Comprehensive Platforms
We provide a wide range of laboratory platforms including in vivo pharmacodynamics, toxicology, and pathogen research. This extensive portfolio allows for integrated study designs, enhancing research efficiency and results.
Global Collaboration
With over 1,000 collaborations with renowned pharmaceutical companies worldwide, we ensure your projects benefit from cutting-edge advancements and diverse approaches in the field of infectious diseases.
Cost Efficiency
Our streamlined processes and expert personnel significantly lower operational costs, providing you with reliable services while helping you maintain a competitive edge in budget efficiency.
Accredited Facilities
Purchasing our CRO infectious disease services ensures you access to AAALAC-accredited laboratories that uphold rigorous standards in animal welfare and research integrity. We are dedicated to providing optimal conditions for all stages of research, which translates to better, reliable results for your projects. Our facilities are equipped with advanced technology and a skilled team of professionals who uphold the highest industry standards, ensuring your research is both ethical and scientifically sound.
Get a Quote
Diverse Research Platforms
At KCI Biotech, we boast a vast array of platforms dedicated to infectious disease research. This means you can access everything from pharmacodynamics and toxicology to molecular biology and imaging services. Our comprehensive approach allows for seamless integration of various methodologies, helping you achieve multifaceted insights into your studies. This diversity not only streamlines project timelines but also enhances the potential for groundbreaking discoveries in treatment and prevention strategies.
Get a Quote

Global Network
With over 1,000 collaborations with top-tier pharmaceutical companies globally, our extensive network facilitates innovative partnerships and knowledge sharing. These collaborations enhance our service delivery by integrating diverse expertise and cutting-edge advancements into your projects. By choosing KCI Biotech, you tap into this global ecosystem, gaining access to insights and resources that are pivotal in tackling complex infectious disease challenges.
Get a QuoteTrusted by Thousands
Hear from those who love our products.
"KCI Biotech exceeded our expectations. Their thorough approach to CRO infectious disease research provided us with results that were not only timely but also of the highest quality."
Jason
"We have been partnering with KCI Biotech for years. Their knowledge in infectious diseases has significantly impacted our R&D projects positively. Highly recommend their services!"
Nicole
"From start to finish, the team at KCI Biotech demonstrated professionalism and a keen understanding of our needs. Their CRO infectious disease services are invaluable!"
Cheryl
Need Help?
Clear and concise answers to your questions.
We offer comprehensive preclinical research services including pharmacodynamics evaluation, toxicology studies, and pathology assessments tailored for infectious disease applications.
Our facilities are AAALAC-accredited, and we adhere to stringent quality control measures at every stage of research and development to ensure the highest standards are met.
Yes, we specialize in custom research projects. Our team works closely with clients to tailor research designs and methodologies that fit specific needs and objectives.